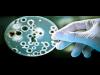

أصدر الدكتور خالد فهمي وزير البيئة توجيهاته بسرعة إرسال لجنة عاجلة لمعاينة البلاغ الوارد لغرفة العمليات المركزية |
كشفت شركة ديل الأمريكية عن 4 أجهزة حواسيب جديدة مخصصة للألعاب معتمدة على معالجات شركة إنتل Kaby Lake، وذلك على هامش |
نجح باحثون أمريكيون بتصميم “مرتبة ذكية” تعدل نفسها ذاتيا للتكيف مع وضعيات الجسم المختلفة، حتى عند رفع رأس النائم |
في أواخر العام الماضي أكدت لنا شركة BMW أنها ذاهبة للكشف عن تكنولوجيا جديدة لعرض المعلومات داخل السيارات تدعى BMW |
توجد الآن 110 شركات، وفي طور التوسع في مناطق المملكة خلال الثلاثة الأشهر المقبلة من خلال افتتاح فروع في الدمام والقصيم وأبها.
ا |
ضربت أسوأ موجة من الفيضانات منذ عام 2006 شمال شرقي ألمانيا مسببة أضرارا خطيرة، وسط توقعات خبراء الطقس بحدوث عواصف في |
الكميوترات المحمولة الهجينة لا تزال تواصل التدفق إلينا من معرض الإلكترونيات الإستهلاكية CES 2017 المنعقد حاليا بمدينة لاس |
اعلنت وزارة الصحة والسكان عن تقدم 12 الف و 75 من الاطباء والفريق الطبى من مختلف التخصصات عبر الموقع الاليكتروني |
أعلن الدكتور أحمد عماد الدين راضي وزير الصحة والسكان عن موافقة مجلس الوزراء على تخصيص مستشفيين |
نجح فريق طبي بمعهد الكبد القومى بجامعة المنوفية في إجراء جراحات لزراعة الكبد لثلاثة أطفال بالمجان تحت رعاية الدكتور
|
التقى الدكتور الهلالى الشربينى وزير التربية والتعليم والتعليم الفني بالدكتور أحمد الجوهرى رئيس الجامعة المصرية اليابانية |
سلسلة الحواسيب الموجهة لعشاق الألعاب Predator من شركة Acer لا تزال تواصل إستقبال أعضاء جدد، فبعدما قامت الشركة |
أعلنت شركة أسوس عن حاسبها الشخصيّ الجديد من نوع كروم بوك Chromebook الذي يحمل اسم Chromebook Flip C302CA الذي |
تزايدت نسبة الاعتماد على الروبوتات في خطوط الإنتاج من قبل الشركات المصنعة، وذلك بهدف تقليل التكاليف الإجمالية للشركات، ومن بينهم شركة Foxconn. |
بدأت شركة سامسونج اليوم بإصدار تحديث جديد للهاتف Galaxy Note 5. هذا التحديث الجديد يبلغ حجمه 295 ميغابايت، وهو متاح |
كشفت "نورتن" التابعة لشركة "سيمانتك" اليوم عن Norton Core، المصمم بطريقة فريدة ومميزة بهدف تحويل مستقبل الأمن الرقمي. |
عقدت شركة الاتصالات السعودية ممثلة في وحدة قطاع الأعمال "قمة STC للحوسبة السحابية" في دبي مؤخرا، والتي جمعت نخبة من |
Hyundai Blue Link هي خدمة مثيرة للإهتمام بالنظر إلى أنها تتيح لملاك سيارات Hyundai التحكم في سياراتهم عن بعد. ومن |
أعلنت شركة "هواوي" عن شحن أكثر من 10 ملايين هاتف ذكي من سلسلة P9 و P9 Plusإلى مختلف أرجاء العالم، لتصبح بذلك أول |
يعتقد كثيرون أن تطبيق المراسلة الفورية "واتساب" أكثر أمانا من غيره، بالنظر إلى استخدام الحساب وفق رقم هاتفي محدد،
|
كشف باحثون فى مستشفى بحوث الأطفال بنيويورك عن وجود طفرة جينية تمكن البكتيريا مقاومة العلاج بالمضادات الحيوية الفعالة. |
يعدّ هاتف 6X الجديد من هونر، والمصمم للمستخدمين من جيل الألفية ممّن يهتمون بالسعر المعقول وباتصال الإنترنت الدائم، |
شركة HP هي من بين الشركات التي تحضر كل عام إلى معرض الإلكترونيات الإستهلاكية CES، ولذلك فليس من المستغرب أن نرى هذه |
أعلنت وزيرة الصحة الفرنسية ماريسول تورين، وقف تسويق منتج “يوفسترول د” المستخدم في علاج نقص فيتامين (د) بعد تسببه في وفاة رضيع يبلغ من العمر عشرة أيام. |
كل عام يضع المؤسس والمدير التنفيذى لشركة فيس بوك مارك زوكربيرج، تحديا جديدا لنفسه ليقوم به، وهذا العام أعلن عبر |
قامت شركة هواوي سابقًا بالإعلان عن هاتفها الذكيّ الجديد Honor 6X الذي يعتبر من أفضل الصفقات بمجال الأجهزة منخفضة الكلفة، |
قامت وزارة البيئة من خلال الادارة العامة للحماية من الضوضاء بتركيب محطة لرصد مستويات الضوضاء البيئية في إحدى المنشآت ا |
إبداعات شركة HP لا تزال متواصلة في معرض الإلكترونيات الإستهلاكية CES 2017 المنعقد حاليا بمدينة لاس فيغاس الأمريكية، فبعدما |
اكد اللواء عاطف يعقوب رئيس جهاز حماية المستهلك, إن الجهاز أحال أيف جوتيه بصفته الممثل القانوني لشركة “أورانج مصر للاتصالات |
– في 1992 قامت ستيلا ليبيك بمقاضاة ماكدونالدز لأنّ قهوتها كانت شديدة السخونة وبالتالي عندما حاولت شربها سقطت عليها |